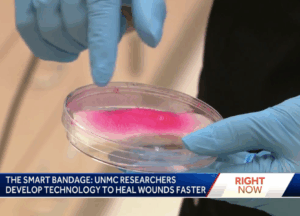

It’s called a smart bandage. Researchers at UNMC say it can heal wounds three times faster than a traditional bandage.
It’s called a smart bandage. Researchers at UNMC say it can heal wounds three times faster than a traditional bandage.
The innovation is in its early stages, but researchers call it promising.
Dr. Sama Abdulmalik is hard at work in the lab of UNMC’s College of Dentistry.
“We’re looking at gene expression using PCR technique,” she said.
Abdulmalik is working to find out how skin responds to a new piece of technology her team is developing. That technology is called a smart bandage.
It’s in the form of a liquid that can be sprayed on the skin. Dr. Sangamesh Kumbar says it uses electrical stimulation to heal the wound.
When KETV visited the lab, the team was testing the technology on samples of pig skin.
“When we cut open any tissue, there is a probability for having infection, there is scarring. This bandage can remove the infection as well as scarring,” Kumbar said.
Kumbar leads the team of 10 researchers.
“We work on various tissues,” Kumbar said.
 They started researching this latest version of the bandage in January and filed a patent a few days ago, so Kumbar cannot say what is in the liquid just yet.
They started researching this latest version of the bandage in January and filed a patent a few days ago, so Kumbar cannot say what is in the liquid just yet.
“We made the material here, we developed the formulation,” he said.
It’s in the early stages, but the team of researchers says it can be a game changer when it comes to healing wounds.
“We need to work even further to reach or make our dream come true,” Abdulmalik said.
– Originally posted by KETV, September 29, 2025. Watch the story here.
